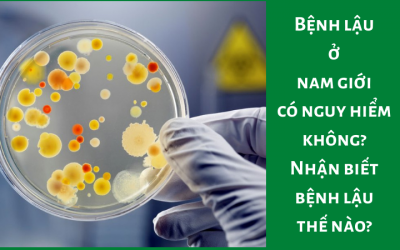

Bệnh lậu mãn tính có quá trình điều trị sẽ phức tạp và khó khăn hơn, nhưng vẫn có thể chữa khỏi nếu người bệnh điều trị đúng phương pháp và tuân theo chỉ định của bác sĩ. Để biết... Xem thêm
Bệnh lậu ở nữ giới có nguy hiểm không? câu trả lời là bệnh lậu nếu không điều trị kịp thời sẽ rất nguy hiểm cho sức khỏe người bệnh. Bệnh lậu trong vòng 1 – 2 tháng sau khởi... Xem thêm
Hiện nay tình trạng bệnh lậu ở nam giới đang có xu hướng gia tăng, thường gặp ở các quý ông trong độ tuổi sinh sản. Vậy bệnh lậu ở nam giới có nguy hiểm không, hãy cùng bác sĩ... Xem thêm
Bệnh lậu nếu không điều trị kịp thời, chỉ sau 1 – 2 tháng từ khi khởi phát sẽ trở thành bệnh lậu mãn tính. Lúc này quá trình điều trị sẽ gặp khó khăn và phức tạp hơn. Hãy... Xem thêm
Bệnh lậu có lây qua qua đường miệng không? Câu trả lời là có, khi vùng miệng có tiếp xúc trực tiếp với vi khuẩn Neisseria gonorrhoeae (song cầu khuẩn lậu) thì đây sẽ một điểm khởi phát của bệnh... Xem thêm
Bệnh lậu gây ra do song cầu khuẩn lậu, khi cơ thể bị nhiễm lậu, vi khuẩn sẽ tấn công ngay vào máu. Do đó “xét nghiệm máu có thể phát hiện bệnh lậu không” câu trả lời là chắc... Xem thêm
Lậu căn bệnh xã hội gặp cả ở nam giới và nữ giới lây truyền chủ yếu qua con đường tình dục. Với những đối tượng có thói quen quan hệ bằng miệng thì vùng khoang miệng sẽ là nơi... Xem thêm
Hiện nay, có nhiều người bệnh cho rằng hết các triệu chứng nhiễm lậu chính là bệnh lậu đã được chữa khỏi. Tuy nhiên theo chia sẻ của các bác sĩ chuyên khoa bệnh lậu chỉ chữa khỏi hoàn toàn... Xem thêm
Triệu chứng đầu tiên lậu ở nam giới có dễ nhận biết không là điều mà rất nhiều người quan tâm. Bệnh lậu là một trong những bệnh lý xã hội lây truyền qua đường tình dục và có thể... Xem thêm
Địa chỉ chữa bệnh lậu ở Hà Nội uy tín và an toàn hiệu quả là điều mà rất nhiều người quan tâm khi không may mắc phải bệnh lý xã hội nguy hiểm này. Bệnh lậu là bệnh lý... Xem thêm